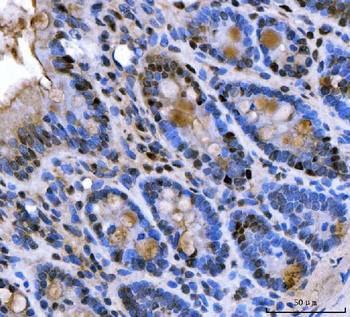
U1A/SNRPA Antibody
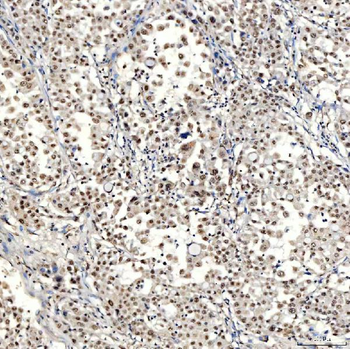
SNRNP40 Antibody

You have no items in your shopping cart.
- Cytokeratin 18/KRT18 Antibody [orb389489]
FC, IF, IHC, WB
Human, Mouse, Rat
Rabbit
Polyclonal
Unconjugated
100 μg - NRF1 Antibody (monoclonal, 2G4) [orb570325]
FC, ICC, IF, IHC, WB
Human
Mouse
Monoclonal
Unconjugated
100 μg - U1A/SNRPA Antibody [orb1474823]
ELISA, ICC, IF, IHC, WB
Human, Mouse, Rat
Rabbit
Polyclonal
Unconjugated
100 μg - SNRNP40 Antibody [orb1474825]
ELISA, FC, ICC, IF, IHC, WB
Human, Mouse, Rat
Rabbit
Polyclonal
Unconjugated
100 μg - TRMT61A Antibody [orb1402053]
ELISA, FC, IF, IHC, WB
Human, Mouse, Rat
Rabbit
Polyclonal
Unconjugated
100 μg - RAB7/RAB7A Antibody [orb1676540]
ELISA, FC, IHC, IP, WB
Human, Mouse, Rat
Rabbit
Polyclonal
Unconjugated
100 μg - ASH2L Antibody [orb1972584]
ELISA, FC, ICC, IF, IHC, WB
Human, Mouse, Rat
Rabbit
Polyclonal
Unconjugated
100 μg - Featured

WB
Human, Mouse, Rat
Canine, Gallus, Hamster, Monkey, Porcine, Rabbit, Sheep
Mouse
Monoclonal
Unconjugated
1 ml, 100 μl, 500 μl, 200 μl - CD8B Rabbit Polyclonal Antibody [orb1269]Featured

IF, IHC-Fr, IHC-P
Human, Mouse, Rat
Equine, Gallus, Guinea pig, Porcine
Rabbit
Polyclonal
Unconjugated
50 μl, 100 μl, 200 μl - Featured

IF, IHC-Fr, IHC-P, WB
Human, Mouse, Rat
Mouse, Rat
Mouse
Monoclonal
Unconjugated
50 μl, 100 μl